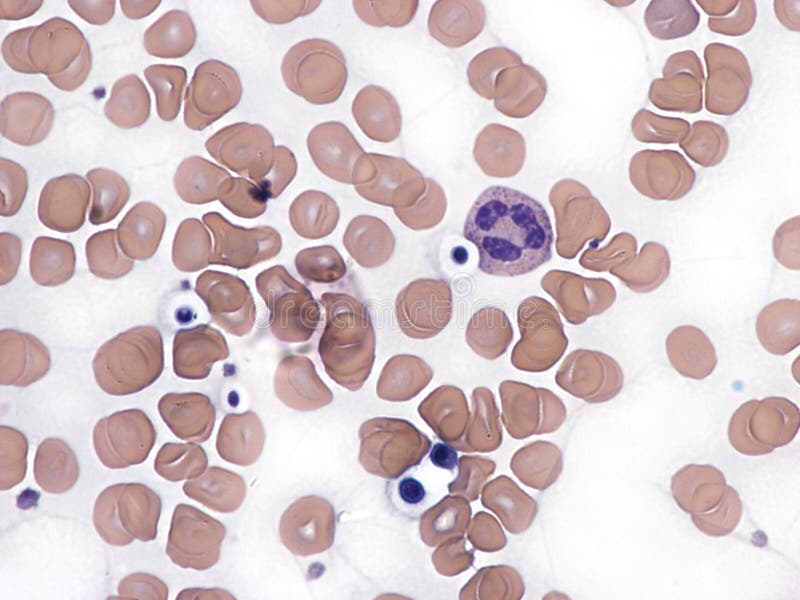
Cryptococcus in peripheral blood smear. royalty free stock image

Royalty-Free Stock Photo
Cryptococcus neoformans is an encapsulated yeast India ink preparetion. Cryptococcus neoformans is an encapsulated fungal organism and it can cause disease in apparently immunocompetent, as well as immunocompromised, hosts
- ?
Size MAX
7006x4912px •
23.4" x 16.4" • @300dpi •
23.4MB • jpg
Author credit line
Image keywords
Related searches
-
Cause Disease
-
Which Can Cause
-
Planting Frangipani
-
White Cambodian
-
Cambodian Plant
-
Bread Yeast Cell
-
Gram Staining
-
Urine Laboratory
-
Urine Gram Stain
-
Budding Yeast Cells
-
Microbiology Beer Lab
-
Yeast Fermentation
-
Science Concept
-
Fluid Smear
-
Body Fluid Smear
-
Encapsulated Virus
-
Blue Lighting
-
Background Gradient
-
Glowing Virus
-
Glowing Particles
-
Beer Yeast Budding
-
Yeast Cells
-
Colorful Abstract
-
Pseudo Hephae
-
Budding Yeast